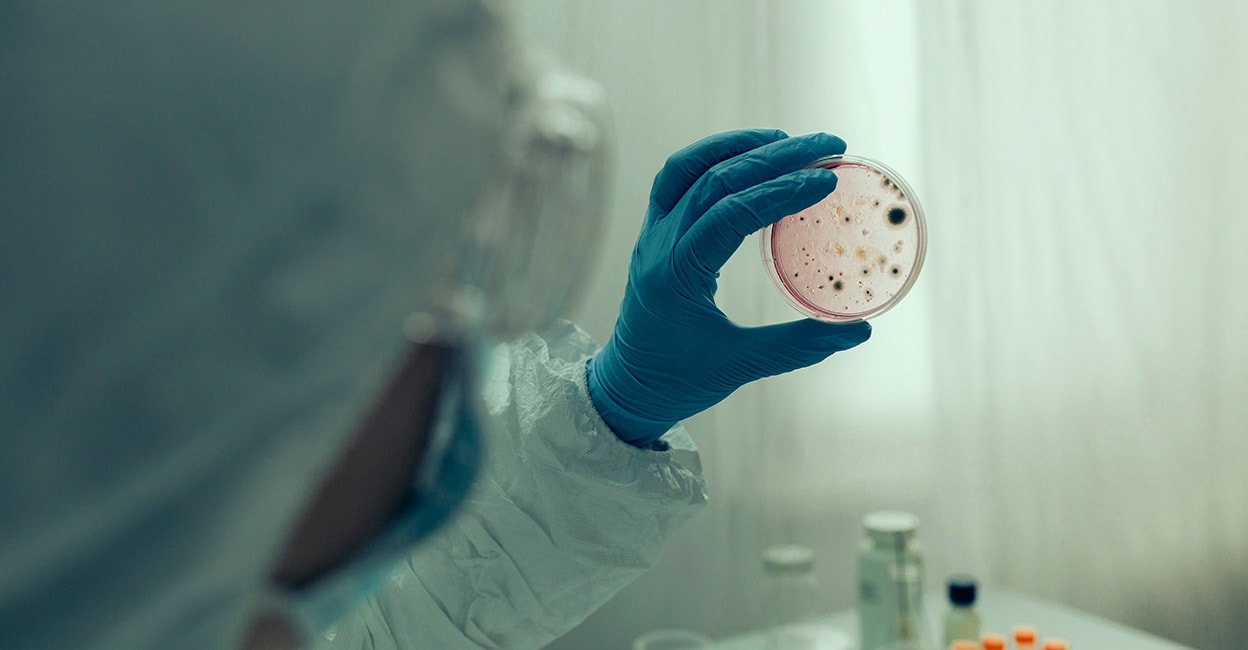

തിരുവനന്തപുരത്ത് കോളറ മരണം: 63കാരൻ മരിച്ചത് 7 ദിവസം മുൻപ്, ആശങ്ക വേണ്ടെന്ന് ആരോഗ്യവകുപ്പ്
തിരുവനന്തപുരം ∙ 7 ദിവസം മുൻപ് തിരുവനന്തപുരത്തെ സ്വകാര്യ ആശുപത്രിയിൽ 63 വയസ്സുകാരൻ മരിച്ചത് കോളറ ബാധയെ തുടർന്ന്. ആരോഗ്യ വകുപ്പിന്റെ വെബ്സൈറ്റിലാണ് ഇതു സംബന്ധിച്ചുള്ള വിവരങ്ങളുള്ളത്.
കവടിയാർ മുട്ടട സ്വദേശിയാണ് കഴിഞ്ഞ 20ന് മരിച്ചത്.
പനി, ഛർദി തുടങ്ങിയ പ്രയാസങ്ങളോടെയായിരുന്നു മുട്ടട സ്വദേശിയെ ആശുപത്രിയിൽ പ്രവേശിപ്പിച്ചത്.
സമീപ കാലത്ത് ഇദ്ദേഹം ദീർഘദൂര യാത്രകൾ നടത്തിയതിന്റെ വിവരങ്ങൾ ലഭ്യമല്ല. കൊല്ലം, തിരുവനന്തപുരം ജില്ലകളിൽ മാത്രമാണ് ഇദ്ദേഹം യാത്രനടത്തിയിട്ടുള്ളത്.
ഇദ്ദേഹത്തിന്റെ കുടുംബാംഗങ്ങൾക്കോ അടുത്ത് സമ്പർക്കം പുലർത്തിയ മറ്റുള്ളവർക്കോ രോഗ ലക്ഷണങ്ങൾ ഇല്ലെന്ന് ആരോഗ്യവകുപ്പ് അറിയിച്ചു. ആവശ്യമായ മുൻകരുതലുകൾ സ്വീകരിച്ചിട്ടുണ്ടെന്നും ആശങ്ക വേണ്ടെന്നും അധികൃതർ അറിയിച്ചു.
അനാഥരും ഭിന്നശേഷിക്കാരുമായവരെ പാർപ്പിക്കുന്ന നെയ്യാറ്റിൻകരയിലുള്ള ഒരു സ്ഥാപനത്തിൽ കഴിഞ്ഞ വർഷം കോളറ വ്യാപനം സ്ഥിരീകരിച്ചിരുന്നു. 2016ലും കേരളത്തിൽ കോളറ മരണം സ്ഥിരീകരിച്ചിരുന്നു.
നിർമാർജനം ചെയ്യപ്പെട്ടു എന്ന പറയപ്പെടുന്ന കോളറ വ്യാപനം ഉണ്ടാകുന്നത് മലിനമായ ആഹാരത്തിലൂടെയും വെള്ളത്തിലൂടെയുമാണ്.
…
FacebookTwitterWhatsAppTelegram
ദിവസം ലക്ഷകണക്കിന് ആളുകൾ വിസിറ്റ് ചെയ്യുന്ന ഞങ്ങളുടെ സൈറ്റിൽ നിങ്ങളുടെ പരസ്യങ്ങൾ നൽകാൻ ബന്ധപ്പെടുക വാട്സാപ്പ് നമ്പർ 7012309231 Email ID [email protected]







